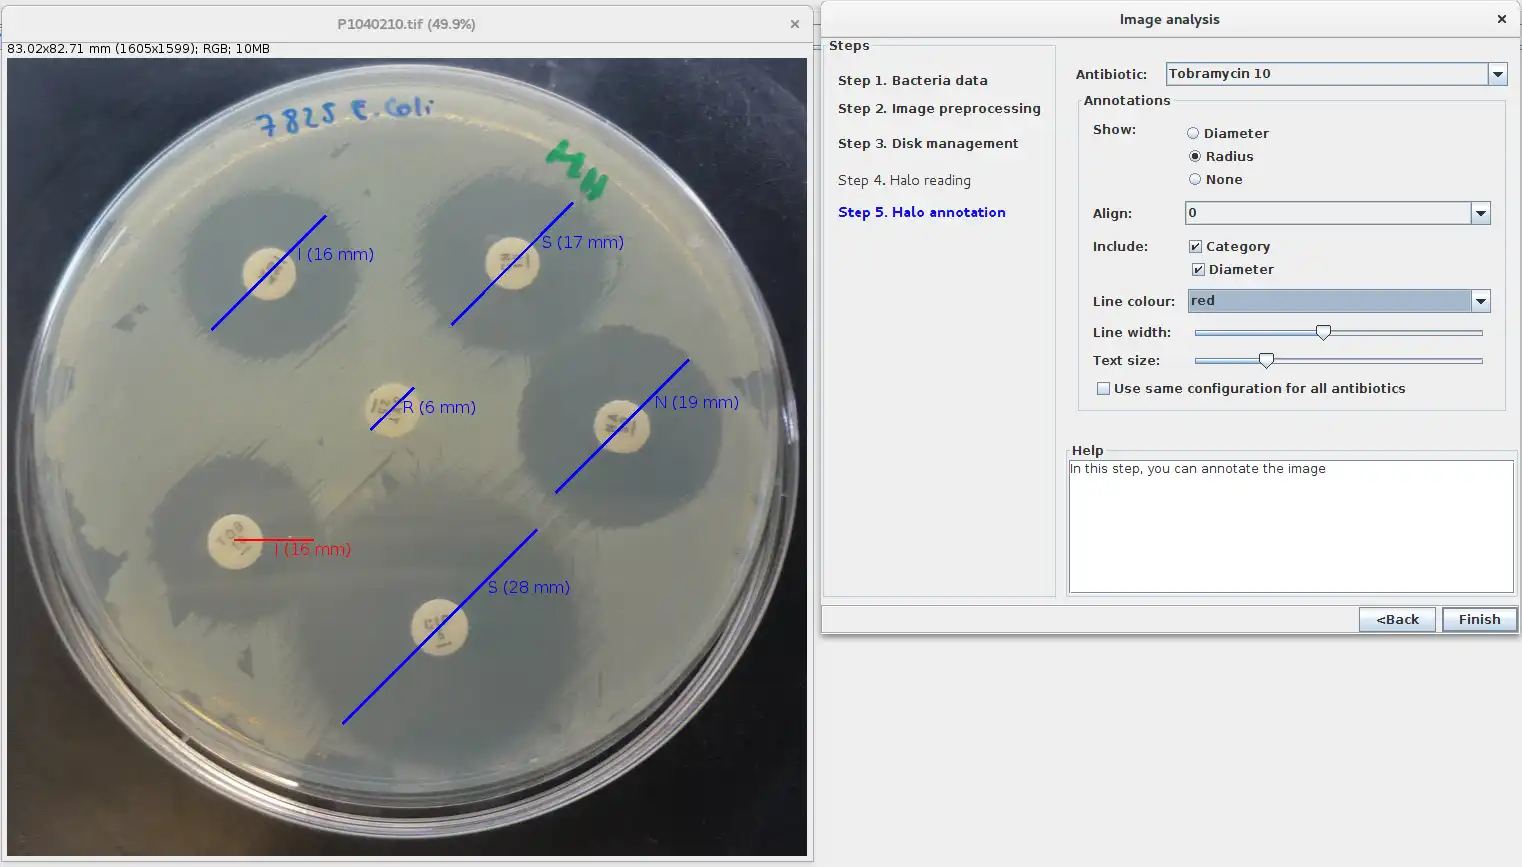

This is the Linux app named AntibiogramJ to run in Linux online whose latest release can be downloaded as AntibiogramJ.zip. It can be run online in the free hosting provider OnWorks for workstations.
Download and run online this app named AntibiogramJ to run in Linux online with OnWorks for free.
Follow these instructions in order to run this app:
- 1. Downloaded this application in your PC.
- 2. Enter in our file manager https://www.onworks.net/myfiles.php?username=XXXXX with the username that you want.
- 3. Upload this application in such filemanager.
- 4. Start the OnWorks Linux online or Windows online emulator or MACOS online emulator from this website.
- 5. From the OnWorks Linux OS you have just started, goto our file manager https://www.onworks.net/myfiles.php?username=XXXXX with the username that you want.
- 6. Download the application, install it and run it.
SCREENSHOTS
Ad
AntibiogramJ to run in Linux online
DESCRIPTION
AntibiogramJ is a Java program for the identification, measurement and categorisation of inhibition zones in antibiogram images captured with any device that incorporates a camera (including digital cameras and mobile phones).Citing AntibiogramJ: A. Alonso, C. Domínguez, J. Heras, E. Mata, V. Pascual, C. Torres, and M. Zarazaga. AntibiogramJ: a Tool for Analysing Images from Disk Diffusion Tests. Computer Methods and Programs in Biomedicine 143:159-169. 2017. DOI: http://dx.doi.org/10.1016/j.cmpb.2017.03.010
You can see more information about AntibiogramJ in https://sourceforge.net/p/antibiogramj/wiki/Home/
Several videos explaining the use of AntibiogramJ are available in https://sourceforge.net/p/antibiogramj/wiki/Videos/
AntibiogramJ includes now the EUCAST v.9.0.
Please address any question or comment to joheras at gmail.com
User interface
Java Swing
Programming Language
Java
Database Environment
SQL-based
This is an application that can also be fetched from https://sourceforge.net/projects/antibiogramj/. It has been hosted in OnWorks in order to be run online in an easiest way from one of our free Operative Systems.